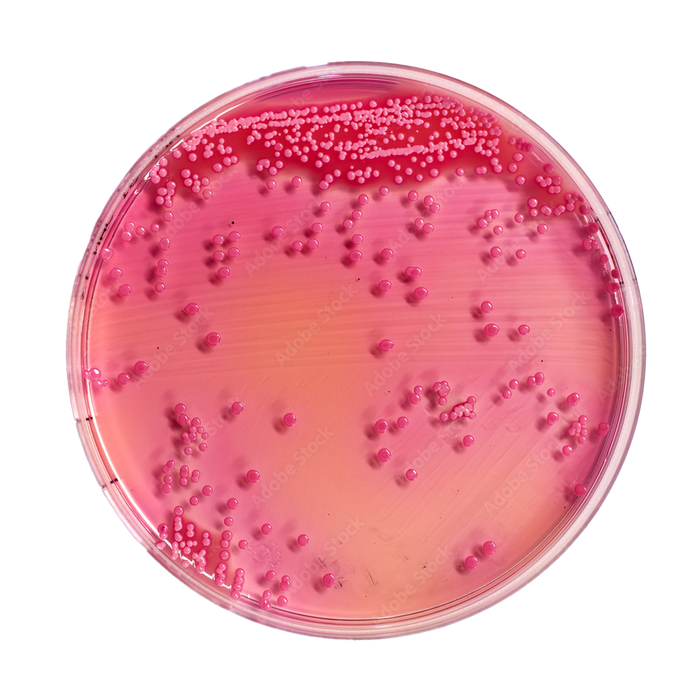

Eine innovative Technologie für die Zahnfleischgesundheit
Parodontitis ist eine der weltweit häufigsten chronischen Erkrankungen – und bisher fehlte ein präziser, mikrobiomfreundlicher Ansatz. PerioTrap entwickelt Inhaltsstoffe, die gezielt die krankmachenden Mechanismen von P. gingivalis blockieren. Damit schaffen wir die Grundlage für moderne Prophylaxe- und Pflegeprodukte, die nicht eliminieren, sondern modulieren.